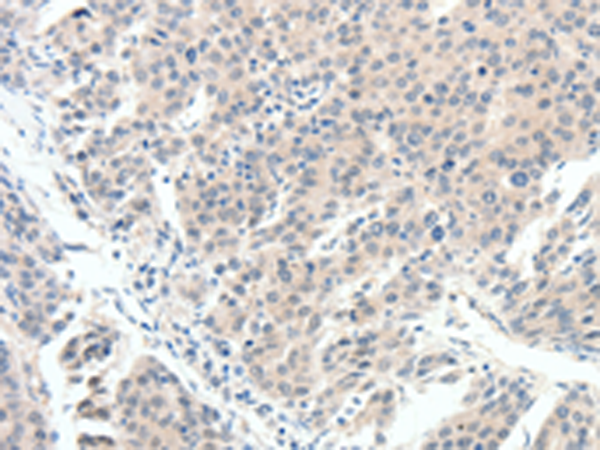

中文名稱: 兔抗SCN10A多克隆抗體
英文名稱: Anti-SCN10A rabbit polyclonal antibody
別 名: PN3; SNS; hPN3; Nav1.8
相關類別: 一抗
儲 存: 冷凍(-20℃)
宿 主: Rabbit
抗 原: SCN10A
反應種屬: Human
標 記 物: Unconjugate
克隆類型: rabbit polyclonal
技術規(guī)格
|
Background: |
The protein encoded by this gene is a tetrodotoxin-resistant voltage-gated sodium channel alpha subunit. The properties of the channel formed by the encoded transmembrane protein can be altered by interaction with different beta subunits. This protein may be involved in the onset of pain associated with peripheral neuropathy. |
|
Applications: |
ELISA, IHC |
|
Name of antibody: |
SCN10A |
|
Immunogen: |
Synthetic peptide of human SCN10A |
|
Full name: |
sodium channel, voltage-gated, type X, alpha subunit |
|
Synonyms: |
PN3; SNS; hPN3; Nav1.8 |
|
SwissProt: |
Q9Y5Y9 |
|
ELISA Recommended dilution: |
1000-2000 |
|
IHC positive control: |
Human breast cancer and Human cervical cancer |
|
IHC Recommend dilution: |
15-50 |
購物車
購物車 幫助
幫助
 021-54845833/15800441009
021-54845833/15800441009
